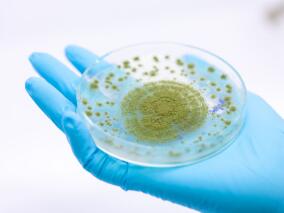
侵袭性曲霉病的死亡率：伏立康唑耐药患者vs伏立康唑敏感患者

-
使用ART治疗的HIV阳性者:COVID-19的发病率和严重性
环球医学资讯
 2020年11月30日
2020年11月30日 点击量:804
点击量:804 1小时条评论
1小时条评论接受抗逆转录病毒治疗(ART)的HIV阳性者中,新冠肺炎(COVID-19)的发病率和严重程度尚未在大规模人群中得到描述。2020年10月,发表在《Ann Intern Med》的一项队列研究,针对该问题在接受ART的77590例HIV阳性者中展开调查。 目的:探讨接受ART治疗的HIV阳性患者使...
-
实体器官和造血细胞移植受者 切莫频繁使用β-内酰胺…
环球医学资讯
 2020年11月26日
2020年11月26日 点击量:233
点击量:233 1小时条评论
1小时条评论beta;-内酰胺类药物是临床上应用最为广泛的抗菌药之一,然而该类药物易发生过敏反应的特点,常常是限制其临床使用的原因。2020年10月,发表在《Clin Infect Dis》的一项研究则发现,beta;-内酰胺类抗菌药过敏与该类药物的频繁使用有关,接受器官移植术的患者需要进行...
-
美国19~44岁的社区念珠菌血症患者 使用注射毒品或…
环球医学资讯
 2020年11月26日
2020年11月26日 点击量:299
点击量:299 1小时条评论
1小时条评论近年来,人类在医疗过程中大量使用抗生素、免疫抑制剂及皮质类固醇激素,以及医疗导管等高新技术的应用,导致念珠菌病呈明显上升趋势。2020年10月,发表在《Clin Infect Dis》的一项研究,调查了2014年~2017年美国念珠菌病流行病学的变化。 背景和目的:IDU是念珠...
-
大肠杆菌引起的细菌性尿路感染 临床表现如何?
环球医学资讯
 2020年11月26日
2020年11月26日 点击量:350
点击量:350 1小时条评论
1小时条评论细菌性尿路感染(bUTI)中,大肠杆菌的临床表现仍然不明确。2020年10月,发表在《BMC Infect Dis》的一项研究显示,大部分大肠杆菌菌血症患者有尿液来源。有相当比例的bUTI病例在病史上均未引起泌尿症状。老年人和谵妄患者更有可能出现无尿路症状的bUTI。 背景:bUT...
-
HCV感染者这一指标水平降低 预示着结局不良
环球医学资讯
 2020年11月25日
2020年11月25日 点击量:238
点击量:238 1小时条评论
1小时条评论病毒性肝炎是比较常见的传染病。丙型肝炎病毒(HCV)更是被称为隐匿的杀手。2020年10月,发表在《J Infect》的一项系统评价和荟萃分析显示,循环维生素D减少能反映出HCV感染的不良后果。 目的:本研究旨在阐明循环维生素D水平与HCV感染严重程度的相关性。 方法:研...
-
生殖支原体中与大环内酯类和氟喹诺酮类耐药相关的突…
环球医学资讯
 2020年11月24日
2020年11月24日 点击量:190
点击量:190 1小时条评论
1小时条评论生殖支原体常导致男性尿道炎,女性尿道炎和宫颈炎。2020年11月,澳大利亚、中国、丹麦等国学者发表在《Lancet Infect Dis》的一项系统评价和Meta分析,考察了生殖支原体中与大环内酯类和氟喹诺酮类耐药相关的突变率。 背景:现在,生殖支原体被认为是一种重要的细菌...
-
警示!医院停用VRE接触预防措施 VRE血流感染率上升
环球医学资讯
 2020年11月18日
2020年11月18日 点击量:410
点击量:410 1小时条评论
1小时条评论接触预防措施对医院万古霉素耐药肠球菌(VRE)控制非常重要。2020年10月,发表在《Clin Infect Dis》的一项准实验研究显示,2009~2018年加拿大安大略省医院停用VRE接触预防措施与VRE血流感染率上升相关。 背景和目的:自2012年以来,在加拿大安大略省,一些医院停...
-
预防川崎病高危患者冠状动脉异常 静脉免疫球蛋白+糖…
环球医学资讯
 2020年11月13日
2020年11月13日 点击量:271
点击量:271 1小时条评论
1小时条评论近年来,糖皮质激素治疗川崎病(KD)被研究的如火如荼,而糖皮质激素可作为预测静脉注射免疫球蛋白无反应和冠状动脉病变高风险患儿的初始治疗。2020年9月,发表于《J Am Heart Assoc》的一项研究,则发现初始静脉注射免疫球蛋白中添加糖皮质激素的联合治疗可将冠状动...
-
根除囊性纤维化患者的铜绿假单胞菌:静脉vs口服抗生素
环球医学资讯
 2020年11月10日
2020年11月10日 点击量:278
点击量:278 1小时条评论
1小时条评论囊性纤维化是北欧血统人群中最常见的、威胁生命的常染色体隐性遗传性疾病,在其他种族中报道较少。2020年10月,英国学者发表在《Lancet Respir Med》的一项随机对照试验,考察了静脉vs口服抗生素根除囊性纤维化中的铜绿假单胞菌的有效性和安全性。 背景:铜绿假单胞...
-
侵袭性曲霉病的死亡率:伏立康唑耐药患者vs伏立康唑…
环球医学资讯
 2020年11月06日
2020年11月06日 点击量:723
点击量:723 1小时条评论
1小时条评论三唑类药物是目前侵袭性曲霉病(IA)的一线药物,在 IA 治疗中发挥重要作用。但其耐药也逐年增加,成为令人担忧的临床问题。2019年4月,发表于《Clin Infect Dis》的一项多中心回顾性队列研究,考察了侵袭性曲霉病的伏立康唑耐药性和死亡率。 背景:三唑耐药性是IA...

会员登录
会员登录

